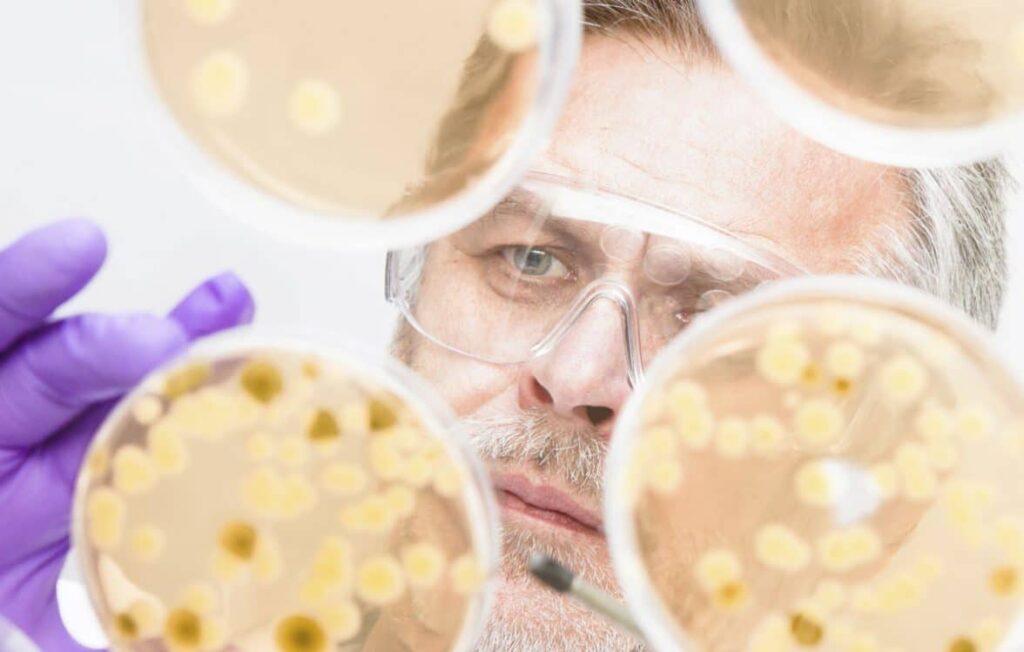

Anthura and KeyGene Establish a Long-Term Strategic Collaboration
Anthura BV, global marketer of anthurium and orchids, and Keygene N.V., a global molecular genetics company devoted to crop innovation, announce that they have entered into a long-term strategic collaboration […]
DuPont Pioneer Gains Exclusive License for Genome Editing Technology
DuPont Pioneer announces a technology license and research collaboration agreement with Lithuania’s Vilnius University to further the technical and commercial utility of guided Cas9 genome editing technology. Under the agreement, DuPont […]
Better Switchgrass, Better Biofuel
Using switchgrass to produce biofuel is one way to decrease the United States’ dependence on oil, but growing it and making it profitable can be complicated. Researchers are trying to change […]
Scientists Use Molecular ‘Lock and Key’ for Potential Control of GMOs
UC Berkeley researchers have developed an easy way to put bacteria under a molecular lock and key in order to contain its accidental spread. The method involves a series of […]
Jerry Monk Named ASTA Honorary Member

Some might say he grew up in the seed industry but this 44-year veteran credits much of his success to those around him and those leaders who set the stage […]
ASTA Honors Two with Distinguished Service Award

Greg Lamka and Betsy Peterson were recognized at The American Seed Trade Association’s 132nd Annual Convention June 19 with the Distinguished Service Award. This award recognizes individuals who have made […]
Researchers Find Gene That Controls Soybean Seed Permeability, Calcium Content
Purdue University researchers have pinpointed the gene that controls whether soybean seed coats are hard or permeable — a finding that could be used to develop better varieties for southern […]
Research Program to Advance Development of Key Bioenergy Crop
The Donald Danforth Plant Science Center announces it’s been awarded an $8 million grant from the U.S. Department of Energy ARPA–E TERRA program. Funds will be used for research to accelerate […]
SynTech Research and Symbiotic Research Announce Strategic Alliance
Kansas-based agrochemical and biotechnology firm SynTech Research and New Jersey’s Symbiotic Research LLC, a laboratory-based life sciences contract research organization, announce an exclusive strategic alliance agreement. SynTech already provides evaluation […]
Legumes Control Infection of Nodules by Both Symbiotic and Endophytic Bacteria
Researchers in Denmark demonstrate that when legume plants are exposed to mixed bacterial communities, they selectively regulate access and accommodation of bacteria occupying a specialized environmental niche — the root nodule. […]
CFI Announces Appointment of New President and CEO
The Canadian Fertilizer Institute (CFI) board of directors announces the appointment of Garth Whyte as president and chief executive officer. The Canadian Fertilizer Institute (CFI) represents manufacturers, wholesale and retail distributors […]
ASTA Chairman Calls for Continued Advocacy

During the gala banquet at the American Seed Trade Association’s 132nd Annual Convention, Chairman John Schoenecker recognized industry leaders and thanked them for their service. He also urged members and […]
Agriculture Secretary Calls on Industry to Educate Congress About the Need for Research

Yesterday, June 18, U.S. Department of Agriculture Secretary Tom Vilsack addressed concerns about the proposed budget cuts to research and asked those in the seed industry to help educate friends […]
The Vulgar Act of Vilifying Farmers

Farmers are often vilified for their work, but this article looks at why this is wrong and how we can support them. Learn why vilifying farmers is wrong and how to support them.
Natural From the Ground Up
Organic farming is a sustainable way to produce food. Learn how to grow your own food with natural methods from the ground up.
The Yield Race

The Yield Race: Learn how European companies are competing to offer the highest yields to investors. Discover the strategies and risks involved.
Samantha Sisk of AgReliant Genetics Named Future Giant of the seed industry

Seed World, in partnership with the Future Seed Executives recognized Samantha Sisk, corporate communications manager at AgReliant Genetics, with the Future Giants award at the American Seed Trade Association’s 132nd […]
ASTA Members “Storm the Hill”
Seed industry representatives from across the country and across industry sectors came together June 17-18 to meet with policymakers in Washington, D.C., as part of the American Seed Trade Association’s […]
Illinois Soybean Association Gathers Experts to Discuss Future Ag Biotechnology Solutions
The Illinois Soybean Association (ISA) is hosting the International Biotechnology Symposium on Aug. 31, in Bloomington, Illinois. The goal of the half-day event is to bring together international agricultural stakeholders to […]
Researchers Study Diversity Among Nitrogen-Fixing Plants
Researchers at California’s Chapman University and Columbia University in New York are focusing on a question that has intrigued scientists for decades — are plants able to regulate their relationships […]
Arcadia Biosciences, Phytola Join Forces to Increase Oil Content in Soybeans
Arcadia Biosciences, a California-based agricultural biotechnology company, announces a collaboration with Canada’s Phytola, a leader in oilseed crop research, to develop soybean varieties with increased oil content. The research and […]
Federal Government Ratifies UPOV 91

The Government of Canada makes official its ratification of the 1991 Act of the International Convention for the Protection of New Varieties of Plants (UPOV 91). The purpose of UPOV is […]
PBA Offering First Open Enrollment Advanced Module Course
Responding to the demand of the plant breeding community, the University of California, Davis Plant Breeding Academy is offering its first open enrollment Advanced Module course. The class will take place […]
Ceres Continues Realignment Toward Food and Feed Markets, Biotech Traits
California’s Ceres Inc., an agricultural biotechnology company, announces the continued realignment of its business to focus on food and forage opportunities and biotechnology traits for sugarcane and other crops. As part […]
Monsanto-Syngenta Merger Could Hike Seed Prices, NFU Says
National Farmers Union (NFU) releases a resolution passed by its board of directors opposing the potential merger between agricultural giants Monsanto and Syngenta. The merger, if achieved, would combine the […]
Seed Supporter

Learn how Seed Supporter is helping to improve the lives of farmers in Europe. Read about the organization’s mission and how it is making a difference in the agricultural industry.
Brave New World

Explore the brave new world of Europe in 2015: a continent of diverse cultures, languages, and customs. Discover the unique beauty of Europe and its people.
Company Seeds For Smallholder Farmers’ Needs

Smallholder farmers in Europe are in need of company seeds to help them increase their yields. This article explains how companies can help meet this need.
Company Seeds For Smallholder Farmers’ Needs

Smallholder farmers in Europe need help to increase their yields. Company Seeds provides a solution by providing quality seeds and training to farmers.
Ensuring Biodiversity

Protecting biodiversity is essential for a healthy planet. Learn how to conserve species and habitats with sustainable practices.
Wheat Genome Sequencing Catching up

Wheat genome sequencing is making strides in Europe, with new research and technology helping to unlock the secrets of this important crop. Learn more about this breakthrough.
China and its Relationship with Seed

China’s relationship with SEED has been growing since the early 2000s. This article explores the history of the partnership and its implications for the future.
Bringing Biotechnology to China

Bringing biotechnology to China: Learn how a Canadian company is helping to revolutionize the Chinese biotechnology industry.
Why Crop Diversity Matters

Crop diversity is essential for sustainable agriculture. Learn why it’s important and how it can help protect the environment and ensure food security.
Industry Efforts to Protect Bee Health are Paying Off: CSTA

_x000D_ _x000D_ _x000D_ _x000D_ _x000D_ _x000D_ _x000D_ Numbers hot off the press from Health Canada’s Pest Management Regulatory Agency (PMRA) show that the seed industry’s unprecedented action to protect bee […]
Syngenta Announces Launch of Clariva pn Seed Treatment
Syngenta Canada announces the registration and launch of Clariva pn seed treatment, a new biological seed treatment that provides growers with an important tool in the management of soybean cyst […]
